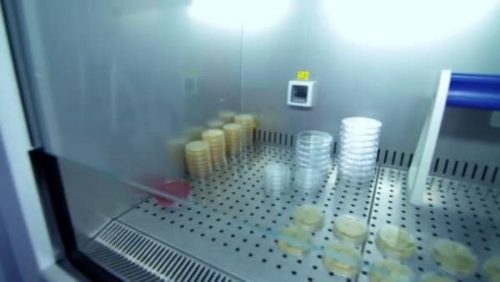

При сильных морозах вирусы COVID-19 «задерживаются» в вязком воздухе, поэтому опасность заразиться возрастает.
Ведущие мировые эксперты провели исследования, чтобы выяснить, боится ли коронавирус морозов. Исследования показали, что COVID-19 сохраняет свою активность независимо от того, сколько «минусов» на столбике термометра. А некоторые ученые и вовсе считают, что в минусовую температуру вирус не просто выживает, но и может «жить» до двух лет. Так, был развеян миф, что низкие температуры способны его побороть. В частности, немецкий ученый Гюнтер Кампф говорит, что пониженная температура воздуха только продлевает жизнь болезнетворного агента.
Ученые из Китая назвали оптимальные условия для передачи коронавируса. Для COVID-19 это +5+10С тепла, при влажности окружающей среды 35-50%. При увеличении показателя термометра активность вируса существенно снижалась, а при +30С свелась к нулю.
Российский ученый - доктор биологических наук Сергей Нетесов разводит руками: если бы мороз негативно влиял на вирусы, они бы все умерли еще зимой, но, увы, это не так. Оптимальным градусом для большинства штаммов является -80 С. Соответственно, при других минусовых температурах (выше -80 С) патоген не только не умирает, но и прекрасно сохраняется, делая свое черное дело.
Роспотребнадзор, ссылаясь на данные своих исследований, утверждает, что передача коронавируса происходит в любых районах страны, независимо от температуры и особенностей климата, сообщает med-post.ru. Так что количество зараженных не зависит от жары или мороза. Возбудитель не гибнет даже в снежную погоду, так как температура тела человека сохраняется в пределах 36-37 С независимо от окружающей среды.
Врач высшей категории Владимир Зайцев рассказал, что при низкой температуре частички вируса могут дольше задерживаться в воздухе. Такое необычное предупреждение сделал главный врач ЛОР-клиники Владимир Зайцев в преддверие наступления зимы.
«Морозный воздух более вязкий. Если мы говорим о воздушно-капельном пути передаче, то капля больше 5 микрон опускается вниз, она падает, капля меньше 5 микрон с выдыхаемым воздухом летит на собеседника, когда тот чихнули или дыхнули. Если мы говорим про теплую, плюсовую погоду, то частички размером 5 микрон и выше достаточно быстро оседают, а при морозном воздухе, чем мороз сильнее, в этом случае частицы летают в воздухе и вероятность их вдохнуть другим человеком выше. Порой мы видим даже белую дымку от морозного воздуха", - цитирует ТАСС медика.
В то же время Зайцев обращает внимание на то, что в морозную погоду желательно вообще не разговаривать с собеседником на улице как раз из-за риска заразиться ковидом, поскольку в воздух попадает больше вирусных частиц. И не просто попадают, но и, как выясняется, «задерживаются». Однако при повышенной вероятности заразиться - «поймать» частицы вируса можно в случаях, когда зараженный человек чихает или разговаривает, а собеседник вдруг зевнул или вовсе слушает визави с открытым ртом. Ситуация благоприятная для ковида еще и потому, что с наступлением холодов у людей организм вообще слабеет, они чаще болеют.
«На фоне простудных явлений и коронавирусную инфекцию поймать достаточно легче, она легче задержится в организме и останется там», - говорит медик, призывая россиян одеваться тепло и быть осторожными.
Зайцев предупреждает, что пандемия не идет на спад, так что очень многое зависит от поведения самих граждан и их отношения к своему здоровью. "Блокнот" ежедневно публикует динамику коронавируса, по которой можно видеть, что ситуация далека от улучшения. В связи с ухудшающейся эпидемиологической ситуацией мэр Москвы Сергей Собянин ввел дополнительные ограничения, отменил все рождественские ярмарки и новогодние мероприятия.
В свою очередь популярный доктор Евгений Комаровский утверждает, что человечество просто должно смириться, что коронавирус будет в нашей жизни всегда, поэтому "надо учиться жить с ним". А Далай-лама и вовсе призвал не "париться" насчет COVID-19, считая, что не стоит волноваться из-за того, что мы изменить не можем, а если можем, то лучше в таком случае приложить силы, чтобы изменить это.